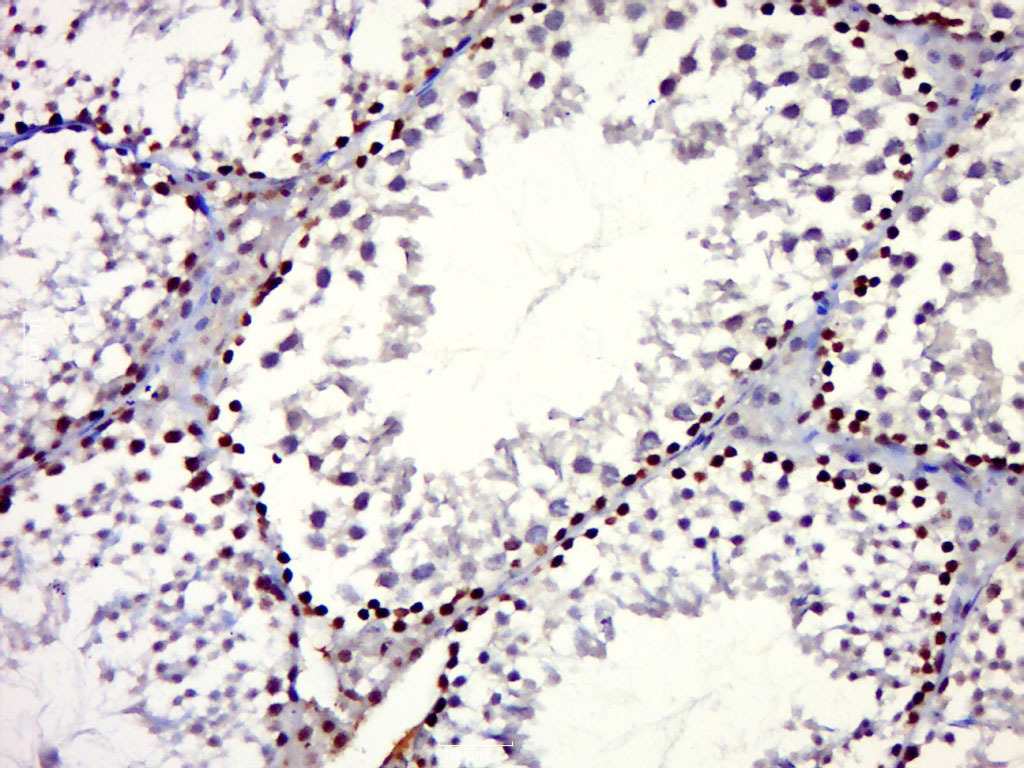
verifiedActivity

购物车
 您的购物车当前为空
您的购物车当前为空
Anti-nNOS Polyclonal Antibody 是一种 Rabbit 抗体,靶向 Cellubrevin。Anti-nNOS Polyclonal Antibody 可用于 IF,IHC-Fr,IHC-P,WB。
别名 Peptidyl-cysteine S-nitrosylase NOS1, NOS1, NOS type I, nNOS), N-NOS, Nitric oxide synthase, brain, Neuronal NOS(N-NOS, neuronal Nitric Oxide Synthase, NC-NOS, EC:1.14.13.39, Constitutive NOS, bNOS
Anti-nNOS Polyclonal Antibody 是一种 Rabbit 抗体,靶向 Cellubrevin。Anti-nNOS Polyclonal Antibody 可用于 IF,IHC-Fr,IHC-P,WB。
| 规格 | 价格 | 库存 | 数量 |
|---|---|---|---|
| 50 μL | ¥ 1,170 | 5日内发货 | |
| 100 μL | ¥ 1,970 | 5日内发货 | |
| 200 μL | ¥ 2,790 | 5日内发货 |
TargetMol的所有产品仅用作科学研究或药证申报,不能被用于人体,我们不向个人提供产品和服务。请您遵守承诺用途,不得违反法律法规规定用于任何其他用途。
| 产品描述 | Anti-nNOS Polyclonal Antibody is a Rabbit antibody targeting Cellubrevin. Anti-nNOS Polyclonal Antibody can be used in IF,IHC-Fr,IHC-P,WB. |
| 别名 | Peptidyl-cysteine S-nitrosylase NOS1, NOS1, NOS type I, nNOS), N-NOS, Nitric oxide synthase, brain, Neuronal NOS(N-NOS, neuronal Nitric Oxide Synthase, NC-NOS, EC:1.14.13.39, Constitutive NOS, bNOS |
| Ig Type | IgG |
| 反应种属 | Mouse(predicted:Human,Rat,Chicken,Dog,Pig,Cow,Sheep) |
| 验证活性 | 1. Sample: Hela (Human) Cell Lysate at 30 μg MCF-7 (Human) Cell Lysate at 30 μg A549 (Human) Cell Lysate at 30 μg RAW246.7 (Mouse) Cell Lysate at 30 μg Primary: Anti-nNOS (TMAB-01250) at 1/300 dilution Secondary: IRDye800CW Goat Anti-Rabbit IgG at 1/20000 dilution Predicted band size: 130 kDa Observed band size: 130 kDa 2. Sample: Testis (Mouse) Lysate at 40 μg Primary: Anti-nNOS (TMAB-01250) at 1/300 dilution Secondary: IRDye800CW Goat Anti-Rabbit IgG at 1/20000 dilution Predicted band size: 130 kDa Observed band size: 130 kDa 3. Paraformaldehyde-fixed, paraffin embedded (Mouse testis); Antigen retrieval by boiling in sodium citrate buffer (pH6.0) for 15 min; Block endogenous peroxidase by 3% hydrogen peroxide for 20 min; Blocking buffer (normal goat serum) at 37°C for 30 min; Antibody incubation with (nNOS) Polyclonal Antibody, Unconjugated (TMAB-01250) at 1:500 overnight at 4°C, followed by a conjugated secondary for 20 min and DAB staining. 4. Sample: Cerebrum (Mouse) Lysate at 40 μg Primary: Anti-nNOS (TMAB-01250) at 1/1000 dilution Secondary: IRDye800CW Goat Anti-Rabbit IgG at 1/20000 dilution Predicted band size: 130 kDa Observed band size: 150 kDa |
| 应用 | IFIHC-FrIHC-PWB |
| 推荐剂量 | WB: 1:500-2000; IHC-P: 1:100-500; IHC-Fr: 1:100-500; IF: 1:100-500 |
| 抗体种类 | Polyclonal |
| 宿主来源 | Rabbit |
| 亚细胞定位 | Cell membrane, sarcolemma; Peripheral membrane protein. Cell projection, dendritic spine. Note=In skeletal muscle, it is localized beneath the sarcolemma of fast-twitch muscle fiber by associating with the dystrophin glycoprotein complex. In neurons, enriched in dendritic spines (By similarity). |
| 组织特异性 | Isoform 1 is ubiquitously expressed: detected in skeletal muscle and brain, also in testis, lung and kidney, and at low levels in heart, adrenal gland and retina. Not detected in the platelets. Isoform 3 is expressed only in testis. Isoform 4 is detected |
| 构建方式 | Polyclonal Antibody |
| 纯化方式 | Protein A purified |
| 性状 | Liquid |
| 缓冲液 | 0.01M TBS (pH7.4) with 1% BSA, 0.02% Proclin300 and 50% Glycerol. |
| 浓度 | 1 mg/mL |
| 研究背景 | The protein encoded by this gene belongs to the family of nitric oxide synthases, which synthesize nitric oxide from L-arginine. Nitric oxide is a reactive free radical, which acts as a biologic mediator in several processes, including neurotransmission, and antimicrobial and antitumoral activities. In the brain and peripheral nervous system, nitric oxide displays many properties of a neurotransmitter, and has been implicated in neurotoxicity associated with stroke and neurodegenerative diseases, neural regulation of smooth muscle, including peristalsis, and penile erection. This protein is ubiquitously expressed, with high level of expression in skeletal muscle. Multiple transcript variants that differ in the 5' UTR have been described for this gene but the full-length nature of these transcripts is not known. Additionally, alternatively spliced transcript variants encoding different isoforms (some testis-specific) have been found for this gene.[provided by RefSeq, Feb 2011]. |
| 免疫原 | KLH conjugated synthetic peptide: human nNos/NOS-1 |
| 抗原种属 | Human |
| 基因名称 | NOS1 |
| 基因ID | |
| 蛋白名称 | Nitric oxide synthase, brain |
| Uniprot ID | |
| 研究领域 | Germ cell markers,Regulation,Embryonic Germ Cells |
| 功能 | Produces nitric oxide (NO) which is a messenger molecule with diverse functions throughout the body. In the brain and peripheral nervous system, NO displays many properties of a neurotransmitter. Probably has nitrosylase activity and mediates cysteine S-nitrosylation of cytoplasmic target proteins such SRR. |
| 分子量 | Theoretical: 130 kDa. Actual: 150 kDa. |
| 储存方式 | Store at -20°C or -80°C for 12 months. Avoid repeated freeze-thaw cycles. |
| 运输方式 | Shipping with blue ice. |